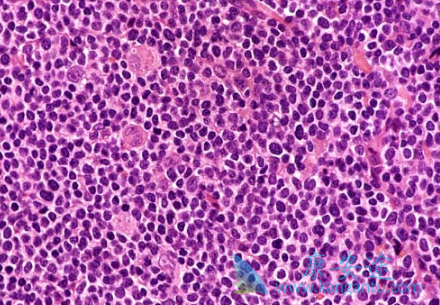
��³����

三项研究展示了酪氨酸激酶(BTK)抑制剂依鲁替尼(IBRUTINIB)在治疗复发/难治性套细胞淋巴瘤(MCL)和淋巴细胞性白血病(CLL)的进展。依鲁替尼单药对MCL的治疗:此项研究是基于370位MCL患者治疗的汇总分析以及3.5年的后续随访得出的,主要是用依鲁替尼治疗,作为三项开放期研究的一部分,其后续随访在三项研究中交叉进行,包括额外的暴露治疗。
该项研究对患者使用依鲁替尼的时间和方式以及暴露时间有具体的要求。在41个月的随访后,患者完全缓解率是26.5%,中位生存期是26.7个月。患者2年总生存率为53%,3年总生存率为45%, 5年总生存率为37% (95%CI, 0.25-0.49)。第一年后新的发病事件减少,最常见的3级以上的TEAEs包括嗜中性白血球减少症(17.0%)、血小板减少症(12.2%)、肺炎(11.9%)、贫血(9.5%)、心房颤动(5.9%)和高血压(5.1%)。
多数出现在依鲁替尼(IBRUTINIB)治疗的一年内。治疗紧急的严重不良事件(SAEs)有229例(61.9%),随时间延长初发病的SAEs降低。此次研究的观察数据是从年老、初患CLL的CLL病人的三期临床研究中得到的。在与苯丁酸氮芥治疗相比的18.4个月中,依鲁替尼单药在患者群体中减少疾病恶化或死亡率达到84%。
详情请访问 肿瘤 https://www.kangantu.com/














请简单描述您的疾病情况,我们会有专业的医学博士免费为您解答问题(24小时内进行电话回访)